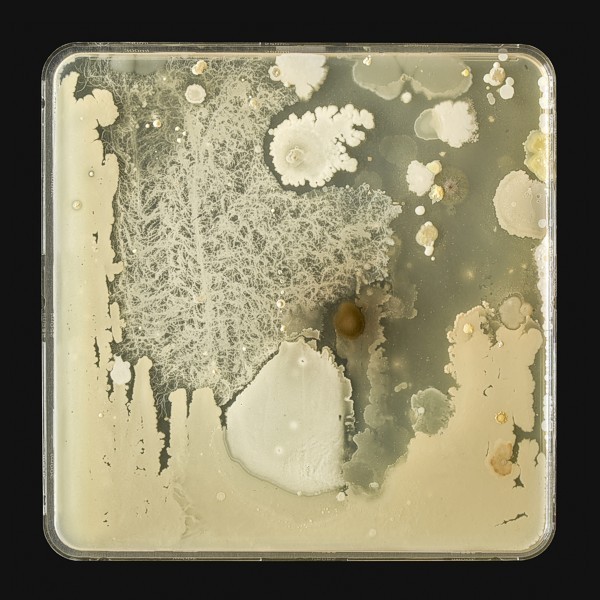

Collection /
Writer-in-Residence Program
In collaboration with U of T Scarborough's Department of English, Creative Writing program
The Doris McCarthy Gallery invites U of T Scarborough's annual Writer-in-Residence to peruse the DMG Permanent Art Collection and identify a work of art to inspire a piece of writing. This literary contribution adds lasting, meaningful layers of interpretation to the work in the collection. Many thanks are owed to the Creative Writing program in the Department of English at U of T Scarborough for the enthusiasm and support they have offered toward this ongoing collaborative project.